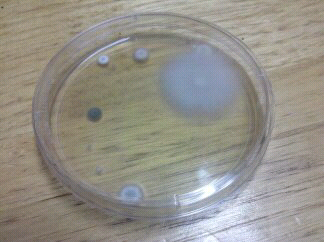

It's Alive!
So if you've been following my posts about the flood we had in our apartment, you know there's been some concerns about the side effects of the water.
The apartment people are replacing our carpet and padding next week, not because it got wet but because "it's old." I guess whatever they need to say to justify it, it needs to be done. The musty smell cannot be tolerated much longer.
Anyways, out of curiosity I purchased a mold test kit and tested the area near where the mail leak occurred. The initial sample was taken on Tuesday and per the instructions I've been letting it sit and do it's thing. So this is how it looks today:
Gross right? I can have the petri dish sent in so the growths can be identified but I'm not sure if I want to do that yet. Any scientists out there who want to take a crack at it?
The apartment people are replacing our carpet and padding next week, not because it got wet but because "it's old." I guess whatever they need to say to justify it, it needs to be done. The musty smell cannot be tolerated much longer.
Anyways, out of curiosity I purchased a mold test kit and tested the area near where the mail leak occurred. The initial sample was taken on Tuesday and per the instructions I've been letting it sit and do it's thing. So this is how it looks today:
Gross right? I can have the petri dish sent in so the growths can be identified but I'm not sure if I want to do that yet. Any scientists out there who want to take a crack at it?

Comments
Post a Comment